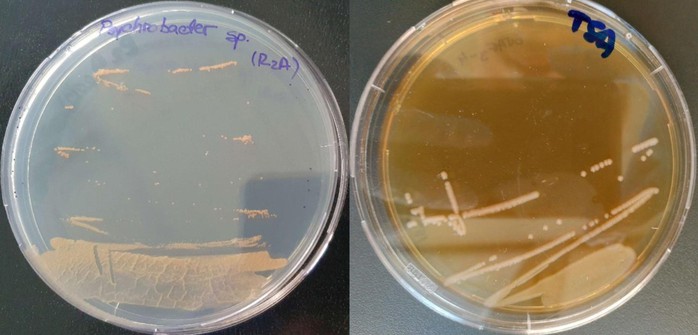
Sinh vật cực nguy hiểm ra từ băng hang động 5.000 năm - Ảnh 1.

Nhóm nghiên cứu dẫn đầu bởi tiến sĩ Cristina Purcarea từ Viện Sinh học Bucharest thuộc Viện Hàn lâm Khoa học Romania đã xác định được một loài sinh vật hoàn toàn mới từ băng hang động, đặt danh pháp là Psychrobacter cryohalolentis.
Nó chỉ là một loài vi khuẩn bé nhỏ nhưng cực kỳ nguy hiểm, vì có khả năng kháng tới 10 loại kháng sinh hiện đại, bao gồm các loại thuốc thường chỉ được dùng cho các bệnh nhiễm trùng nặng như bệnh lao và nhiễm trùng đường tiết niệu.
Vi khuẩn Psychrobacter cryohalolentis là một sinh vật cổ đại cực kỳ nguy hiểm vì có khả năng kháng nhiều loại kháng sinh hiện đại - Ảnh: Frontiers in Microbiology
Theo Sci-News, Psychrobacter là một chi gồm khoảng 50 loài vi khuẩn đã thích nghi về mặt tiến hóa với môi trường lạnh và mặn, được mô tả lần đầu từ năm 1986.
Loài mới nhất Psychrobacter cryohalolentis đã được phân lập từ hang băng Scarisoara ở Romania.
Mặc dù có niên đại lên tới 5.000 tuổi, loài này lại cho thấy khả năng kháng nhiều loại kháng sinh hiện đại và mang hơn 100 gen liên quan đến kháng thuốc, khiến nó trở thành một sinh vật mà y học hiện đại cũng phải lo ngại.
Nhưng có một tin tốt: Nó cũng có thể ức chế sự phát triển của một số loại vi khuẩn kháng kháng sinh cực mạnh đang khiến các nhà khoa học đau đầu. Vi khuẩn này cũng thể hiện các hoạt tính enzyme quan trọng với tiềm năng công nghệ sinh học đáng kể.
Viết trên tạp chí Frontiers in Microbiology, nhóm tác giả cảnh báo phát hiện về sinh vật mới này cho thấy mối nguy tiềm ẩn của hiện tượng nóng lên toàn cầu, làm tan chảy băng vĩnh cửu ở nhiều nơi trên thế giới.
“Nếu băng tan giải phóng những vi sinh vật này, các gene kháng thuốc có thể lây lan sang các vi khuẩn hiện đại, làm trầm trọng thêm thách thức toàn cầu về kháng kháng sinh” - tiến sĩ Purcarea giải thích.
Mặc dù vậy, việc tìm thấy chúng cũng hứa hẹn giúp nhân loại phát triển các loại kháng sinh mới, enzyme công nghiệp và thực hiện các đổi mới công nghệ sinh học khác.

 1 hour ago
1
1 hour ago
1
















 English (US) ·
English (US) ·